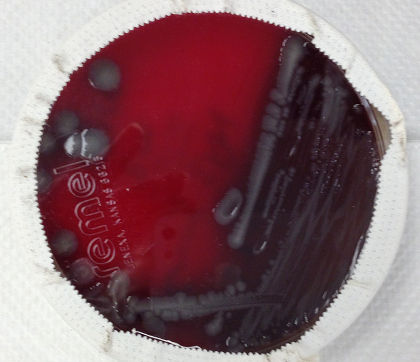
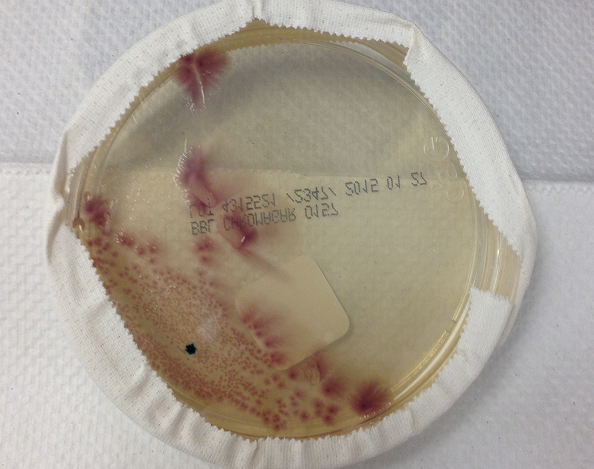

A 60 year old man presented with abdominal pain and bloody diarrhea. He denied fever, chills, nausea, vomiting or recent travel. A stool culture was sent to the microbiology laboratory.

Laboratory Identification:
E. coli O157:H7 is most likely to be detected in the acute phase of illness and may be missed after 5-7 days from onset of symptoms. In general, laboratory identification is based on the detection of Shiga toxin-producing strains or detection of the O157:H7 serotype through various methodologies. In our laboratory, we identified E. coli O157 based on the above gram stain and colony morphology in combination with growth with the appropriate color on a selective plate for E. coli O157, CHROMagar O157. We used our automated microbial identification system, Vitek 2, which performs multiple biochemical reactions to confirm the bacteria as E. coli O157:H7. Additionally, we identified the presence of Shiga toxin through an immunochromatographic lateral flow rapid test using monoclonal antibodies specific to Shiga toxins.
Discussion:
E. coli are gram negative rods that are beta hemolytic, indole positive and lactose fermenters. E. coli is part of the normal colon flora but certain types of E. coli can cause disease depending on their virulence factors. Enterohemorrhagic E. coli (EHEC), also known as Shiga toxin producing E.coli (STEC), is one of six major groups of E. coli that causes diarrhea. EHEC produce a Shiga toxin that inhibits protein synthesis of intestinal epithelial cells via inhibition of the 60S ribosome. The most common serotype is E. coli O157:H7. Transmission occurs through ingestion of raw milk or uncooked ground beef. Hamburgers have been the cause of many outbreaks of infection in the United States although majority of E. coli O157:H7 infections are not associated with outbreaks.
Clinical manifestations from E. coli O157:H7 infection usually occurs at three days from time of exposure but may vary from one to eight days. Clinical symptoms typically begin with abdominal cramps, vomiting, and bloody diarrhea without fever. However, patients may experience a spectrum of disease ranging from asymptomatic infection (less common) to hemorrhagic colitis with progression hemolytic-uremic syndrome (HUS). HUS is the most common cause of acute renal failure in children and results from toxin-mediated damage of endothelial cells in the kidney. HUS is characterized by the triad of acute renal failure, microangiopathic hemolytic anemia, and thrombocytopenia. Supportive therapy is recommended for treatment of E. coli O157:H7 infections. Antibiotics are not recommended because of the potential to increase Shiga toxin production. For this reason, we do not report antibiotic sensitivities for E. coli O157:H7.
Jill Miller, MD is a 2nd year anatomic and clinical pathology resident at the University of Vermont Medical Center.
–Christi Wojewoda, MD, is certified by the American Board of Pathology in AP/CP and Medical Microbiology. She is currently the Director of Clinical Microbiology at the University of Vermont Medical Center and an Assistant Professor at the University of Vermont.

Reblogged this on THE BIOLOGY ELITE.
Gram should be capitalized since it’s the scientist’s name who developed the staining technique.
Good catch!